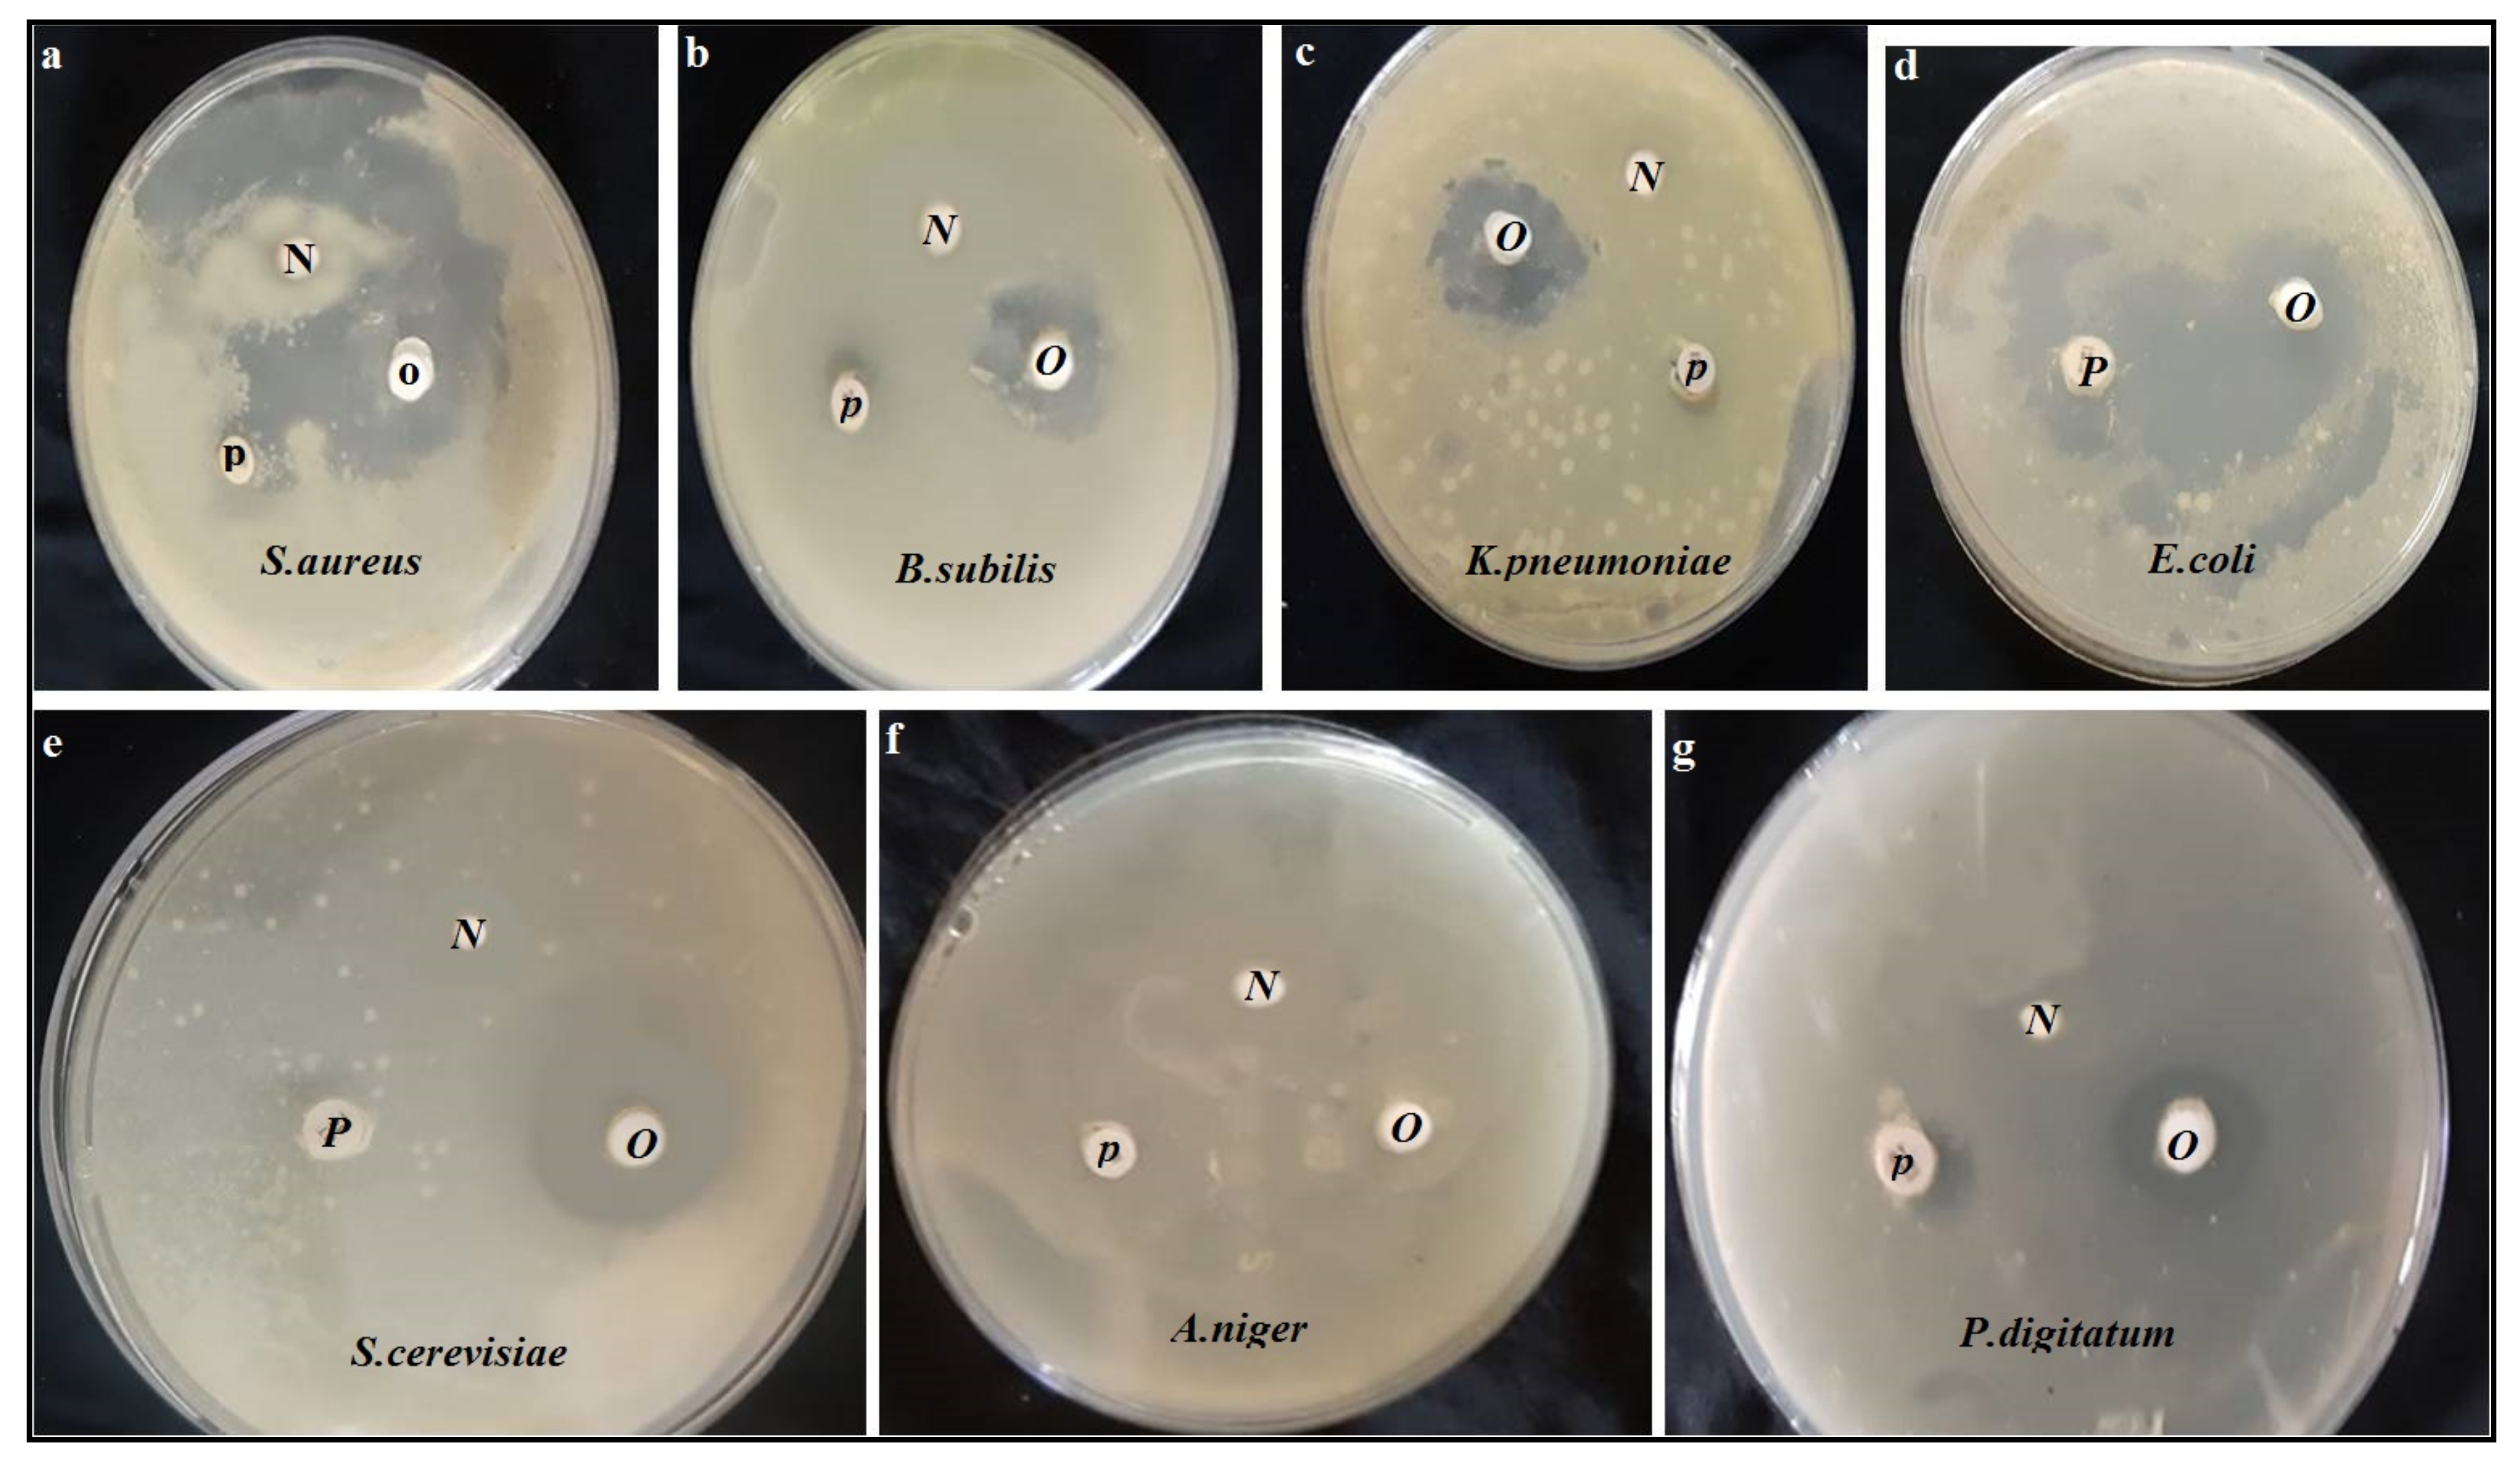
Molecules 27 05453 g002

Chemical Composition and Antioxidant, Antiviral, Antifungal, Antibacterial and Anticancer Potentials of Opuntia ficus-indica Seed Oil
Abstract
1. Introduction
2. Materials and Methods
2.1. Oil Extraction
2.2. Identification of Opuntia ficus-indica Seed Oil
2.2.1. Fatty Acid Composition
2.2.2. Sterols and the Various Components
2.2.3. Tocopherols
2.2.4. Determination of Total Phenolic Compounds
2.3. Antioxidant Activity by Free Radical Scavenging Assay:
2.4. Antimicrobial Activity of Opuntia ficus-indica Seed Oil
2.4.1. Microbial Strains
2.4.2. Antimicrobial Activity
2.4.3. Evaluation of MIC and MBC
2.5. Cytotoxic Assay of Opuntia ficus-indica Seed Oil
2.5.1. Mammalian Cell Line
2.5.2. Cytotoxicity Evaluation
2.5.3. Antiviral Evaluation
2.6. Statistical Analysis
3. Results
3.1. Fatty Acid Composition
3.2. Tocopherol Content
3.3. GC-MS Analysis of Opuntia ficus-indica Seed Oil
3.4. Total Phenolic Contents
3.5. Scavenging Activity against DPPH
3.6. Antimicrobial Activity
3.7. Cytotoxic Activity
3.8. Antiviral Activity
4. Discussion
5. Conclusions
Author Contributions
Funding
Institutional Review Board Statement
Informed Consent Statement
Data Availability Statement
Conflicts of Interest
Sample Availability
References
- Abdallah, H.M.; Almowallad, F.M.; Esmat, A.; Shehata, I.A.; Abdel-Sattar, E.A. Anti-inflammatory activity of flavonoids from Chrozophora tinctoria. Phytochem. Lett. 2015, 13, 74–80. [Google Scholar] [CrossRef]
- Trombetta, D.; Puglia, C.; Perri, D.; Licata, A.; Pergolizzi, S.; Lauriano, E.R.; De Pasquale, A.; Saija, A.; Bonina, F.P. Effect of polysaccharides from Opuntia ficus-indica (L.) cladodes on the healing of dermal wounds in the rat. Phytomedicine 2006, 13, 352–357. [Google Scholar] [CrossRef]
- El Mannoubi, I.; Barrek, S.; Skanji, T.; Casabianca, H.; Zarrouk, H. Characterization of Opuntia ficus indica seed oil from Tunisia. Chem. Nat. Compd. 2009, 45, 616–620. [Google Scholar] [CrossRef]
- Collenette, S. Checklist of Botanical Species in Saudi Arabia; International Asclepiad Society: West Sussex, UK, 1998; p. 78. [Google Scholar]
- Aati, H.; El-Gamal, A.; Shaheen, H.; Kayser, O. Traditional use of ethnomedicinal native plants in the Kingdom of Saudi Arabia. J. Ethnobiol. Ethnomed. 2019, 15, 2. [Google Scholar] [CrossRef] [PubMed]
- Mulas, M.; Mulas, G. Potentialités d’Utilisation Stratégique des Plantes des Genres Atriplex et Opuntia dans la Lutte Contre la Désertification; Université des Études de Sassari: Sassari, Italia, 2004. [Google Scholar]
- Abdel-Hameed, E.S.S.; Nagaty, M.A.; Salman, M.S.; Bazaid, S.A. Phytochemicals, nutritional’s and antioxidant properties of two prickly pear cactus cultivars (Opuntia ficus indica Mill.) growing in Taif, KSA. Food Chem. 2014, 160, 31–38. [Google Scholar] [CrossRef] [PubMed]
- Leo, M.; Abreu, M.B.; Pawlowska, A.M.; Cioni, P.L.; Braca, A. Profiling the chemical content of Opuntia ficus-indica flowers by HPLC–PDAESI-MS and GC/EIMS analyses. Phytochem. Lett. 2010, 3, 48–52. [Google Scholar] [CrossRef]
- Habibi, Y. Contribution à l’Étude Morphologique, Ultrastructurale et Chimique de la Figue de Barbarie. Les Polysaccharides Pariétaux: Charactérisation et Modification Chimique. Ph.D. Thesis, Autre. Université Joseph-Fourier-Grenoble I, Saint-Martin-d’Hères, France, 2004. [Google Scholar]
- Inglese, P. Ecologie, Culture Etutilisations du Figuier De Barbarie; Food and Agriculture Organization of the United Nations (FAO): Rome, Italy, 2019. [Google Scholar]
- Ghazi, Z.; Ramdani, M.; Fauconnier, M.L.; El Mahi, B.; Cheikh, R. Fatty acids sterols and vitamin E composition of seed oil of Opuntia ficus-indica and Opuntia dillenii from Morocco. J. Mater. Environ. Sci. 2013, 4, 967–972. [Google Scholar]
- Simopoulos, A.P. The importance of the ratio of omega-6/omega-3 essential fatty acids. Biomed. Pharmacother. 2002, 56, 365–379. [Google Scholar] [CrossRef]
- Martínez, M.; Penci, M.C.; Marin, M.A.; Ribotta, P.D.; Maestri, D.M. Screw press extraction of almond (Prunus dulcis (Miller) D.A. Webb): Oil recovery and oxidative stability. J. Food Eng. 2013, 119, 40–45. [Google Scholar] [CrossRef]
- Thanonkaew, A.; Wongyai, S.; McClements, D.; Decker, E.A. Effect of stabilization of rice bran by domestic heating on mechanical extraction yield, quality, and antioxidant properties of cold-pressed rice bran oil (Oryza saltiva L.). LWT Food Sci. Technol. 2012, 48, 231–236. [Google Scholar] [CrossRef]
- Teh, S.-S.; Birch, J. Physico-chemical and quality characteristics of cold-pressed hemp 2012, flax and canola seed oils. J. Food Compos. Anal. 2013, 30, 26–31. [Google Scholar] [CrossRef]
- AOAC. Official Methods of Analysis, 15th ed.; Association of Official Analytical Chemists: Washington, DC, USA, 1997; p. 684. [Google Scholar]
- Piironen, V.; Toivo, J.; Lampi, A.-M. Plant sterols in cereals and cereal products. Cereal Chem. 2002, 79, 148–154. [Google Scholar] [CrossRef]
- Mattila, P.; Lampi, A.-M.; Ronkainen, R.; Toivo, J.; Piironen, V. Sterol and vitamin D2 contents in some wild and cultivated mushrooms. Food Chem. 2002, 76, 293–298. [Google Scholar] [CrossRef]
- Kamal-Eldin, A.; Appelqvist, L.; Yosif, G.; Iskander, G.M. Seed lipids of Sesamum indicum and related wild species in Sudan. The sterols. J. Sci. Food Agric. 1992, 59, 327–334. [Google Scholar] [CrossRef]
- Liu, Q.; Scheller, K.K.; Schaefer, D.M. Technical note. A simplified procedure for vitamin E determination in beef muscle. J. Anim. Sci. 1996, 74, 2406–2410. [Google Scholar] [CrossRef][Green Version]
- Singleton, V.L.; Orthofer, R.; Lamuela-Raventos, R.M. Analysis of total phenols and other oxidation substrates and antioxidants by means of Folin–Ciocalteau reagent. Method. Enzymol. 1999, 299, 152–178. [Google Scholar]
- Abu-Zaid, A.A.; Al-Barty, A.; Morsy, K.; Hamdi, H. In vitro study of antimicrobial activity of some plant seeds against bacterial strains causing food poisoning diseases. Braz. J. Biol. 2021, 82, e256409. [Google Scholar] [CrossRef]
- Somchit, M.N.; Reezal, I.; Nur, I.E.; Mutalib, A.R. In vitro antimicrobial activity of ethanol and water extracts of Cassia alata. J. Ethnopharmacol. 2003, 84, 1–4. [Google Scholar] [CrossRef]
- Morales, F.J.; Jiménez-Pérez, S. Free radical scavenging capacity of Maillard reaction products as related to colour and fluorescence. Food Chem. 2001, 72, 119–125. [Google Scholar] [CrossRef]
- Tagg, J.R.; McGiven, A.R. Assay system for bacteriocins. Appl. Microbiol. 1971, 21, 943. [Google Scholar] [CrossRef]
- Vijayan, P.; Raghu, C.; Ashok, G.; Dhanaraj, S.A.; Suresh, B. Antiviral activity of medicinal plants of Nilgiris. Indian J. Med. Res. 2004, 120, 24–29. [Google Scholar] [PubMed]
- Mosmann, T. Rapid colorimetric assay for cellular growth and survival: Application to proliferation and cytotoxicity assays. J. Immunol. Methods 1983, 65, 55–63. [Google Scholar] [CrossRef]
- Randazzo, W.; Piqueras, J.; Rodrıguez-Diaz, J.; Aznar, R.; Sanchez, G. Improving efficiency of viability-qPCR for selective detection of infectious HAV in food and water samples. J. Appl. Microbiol. 2017, 124, 958–964. [Google Scholar] [CrossRef] [PubMed]
- Pinto, R.M.; Diez, J.M.; Bosch, A. Use of the colonic carcinoma cell line CaCo-2 for in vivo amplification and detection of enteric viruses. J. Med. Virol. 1994, 44, 310–315. [Google Scholar] [CrossRef] [PubMed]
- Hu, J.M.; Hsiung, G.D. Evaluation of new antiviral agents I: In vitro prospective. Antivir. Res. 1989, 11, 217–232. [Google Scholar] [CrossRef]
- Al-Salahi, R.; Alswaidan, I.; Ghabbour, H.A.; Ezzeldin, E.; Elaasser, M.M.; Marzouk, M. Docking and antiherpetic activity of 2-aminobenzo[de]-isoquinoline-1,3-diones. Molecules 2015, 20, 5099–5111. [Google Scholar] [CrossRef] [PubMed]
- Liu, W.; Fu, Y.J.; Zu, Y.G.; Tong, M.H.; Wu, N.; Liu, X.L.; Zhang, S. Supercritical carbon dioxide extraction of seed oil from Opuntia dillenii Haw. and its antioxidant activity. Food Chem. 2009, 114, 334–339. [Google Scholar] [CrossRef]
- Tlili, N.; Bargougui, A.; Elfalleh, W.; Triki, S.; Nasri, N. Phenolic compounds, protein, lipid content and fatty acids compositions of cactus seeds. J. Med. Plants Res. 2011, 5, 4519. [Google Scholar]
- Ramadan, M.F.; Mörsel, J.-T. Recovered lipids from prickly pear [Opuntia ficus-indica (L.) Mill] peel: A good source of polyunsaturated fatty acids 4524, natural antioxidant vitamins and sterols. Food Chem. 2003, 83, 447–456. [Google Scholar] [CrossRef]
- Matthäus, B.; Özcan, M.M. Habitat effects on yield, fatty acid composition and tocopherol contents of prickly pear (Opuntia ficus-indica L.) seed oils. Sci. Hortic. 2011, 131, 95–98. [Google Scholar] [CrossRef]
- Zine, S.; Gharby, S.; El Hadek, M. Physicochemical characterization of Opuntia ficus-indica seed oil from Morocco. Biosci. Biotechnol. Res. Asia 2013, 10, 1–7. [Google Scholar] [CrossRef]
- Ramadan, M.F.; Mörsel, J.-T. Oil cactus pear (Opuntia ficus-indica L.). Food Chem. 2003, 82, 339–345. [Google Scholar] [CrossRef]
- Gharby, S.; Harhar, H.; Charrouf, Z.; Bouzobaa, Z.; Boujghagh, M.; Zine, S. Physicochemical composition and oxidative stability of Opuntia ficus-indica seed oil from Morocco. Acta Hortic. 2015, 1067, 83–88. [Google Scholar] [CrossRef]
- Pope, L.E.; Marcelletti, J.F.; Katz, L.R.; Lin, J.Y.; Katz, D.H.; Parish, M.L.; Spear, P.G. The anti-herpes simplex virus activity of n-docosanol includes inhibition of the viral entry process. Antivir. Res. 1998, 40, 85–94. [Google Scholar] [CrossRef]
- El Adib, S.; Slim, S.; Hamdeni, E. Characterization and comparison of the three cultivars seed oil of Opuntia ficus-indica in Tunisia. Indo Am. J. Pharm. Sci. 2015, 2, 967–973. [Google Scholar]
- Nashed, B.; Yeganeh, B.; HayGlass, K.T.; Moghadasian, M.H. Antiatherogenic effects of dietary plant sterols are associated with inhibition of proinflammatory cytokine production in Apo E-KO mice. J. Nutr. 2005, 135, 2438–2444. [Google Scholar] [CrossRef]
- Awad, A.B.; Burr, A.T.; Fink, C. Effect of resveratrol and β-sitosterol in combination on reactive oxygen species and prostaglandin release by PC-3 cells. Prostaglandins Leucot. Essent. Fat. Acids. 2005, 72, 219–226. [Google Scholar] [CrossRef]
- Brand-William, W.; Cuvelier, M.E.; Berset, C. Use of a free radical method to evaluate antioxidant activity. LWT 1995, 28, 25–30. [Google Scholar] [CrossRef]
- Khémiri, I.; Bitri, L. Effectiveness of Opuntia ficus indica L. inermis seed oil in the protection and the healing of experimentally induced gastric mucosa ulcer. Oxid. Med. Cell Longev. 2019, 2019, 1568720. [Google Scholar] [CrossRef]
- Lien, E.J.; Ren, S.; Bui, H.-H.B.; Wang, R. Quantitative structure-activity relationship analysis of phenolic antioxidants. Free Radic. Biol. Med. 1999, 26, 285–294. [Google Scholar] [CrossRef]
- Sindhu, E.R.; Kuttan, R. Carotenoid lutein protects rats from gastric ulcer induced by ethanol. J. Basic Clin. Physiol. Pharmacol. 2012, 23, 33–37. [Google Scholar] [CrossRef] [PubMed]
- Stevenson, D.E. Polyphenols as adaptogens—The real mechanism of the antioxidant effect. In Bioactive Compounds in Phytomedicine; InTech: Rijeka, Croatia, 2012; pp. 143–162. [Google Scholar]
- Atwood, C.S.; Huang, X.; Moir, R.D.; Tanzi, R.E.; Bush, A.I. Role of free radicals and metal ions in the pathogenesis of Alzheimer’s disease. In Metal Ions in Biological Systems: Interrelations Between Free Radicals and Metal Ions in Life Processes; Sigel, A., Ed.; Routledge: London, UK, 1999; Volume 36, pp. 309–364. [Google Scholar]
- Colla, L.M.; Furlong, E.B.; Costa, J.A.V. Antioxidant properties of Spirulina (Arthospira) platensis cultivated under different temperatures and nitrogen regimes. Braz. Arch. Biol. Technol. 2007, 50, 161–167. [Google Scholar] [CrossRef]
- Gershwin, M.E.; Belay, A. Spirulina in Human Nutrition and Health; CRC Press: Boca Raton, FL, USA, 2007; 328p, ISBN 9781420052572. [Google Scholar]
- Sahu, R.K.; Kar, M.; Routray, R. DPPH free radical scavenging activity of some leafy vegetables used by tribals of Odisha, India. J. Med. Plants Stud. 2013, 1, 21–27. [Google Scholar]
- Awad, A.B.; Downie, A.; Fink, C.S.; Kim, U. Dietary phytosterols inhibits the growth and metastasis of MDA-MB-231 human breast cancer cells grown in SCID mice. Anticancer Res. 2000, 20, 821–824. [Google Scholar] [PubMed]
- Sudha, T.; Chidambarampillai, S.; Mohan, V.R. GC-MS analysis of bioactive components of aerial parts of Fluggea leucopyrus Willd. (Euphorbiaceae). J. Appl. Pharm. Sci. 2013, 3, 126–130. [Google Scholar]
- Stuchlı’k, M.; Zak, S. Vegetable lipids as components of functional foods. Biomed. Papers 2002, 146, 3–10. [Google Scholar] [CrossRef]
- Akihisa, T.; Yasukawa, K.; Yamaura, M.; Ukiya, M.; Kimura, Y.; Shimizu, N.; Arai, K. Triterpene alcohol and sterol ferulates from rice bran and their anti-inflammatory effects. J. Agric. Food Chem. 2000, 48, 2313–2319. [Google Scholar] [CrossRef]
- Ouyang, H.; Kong, X.; He, W.; Qin, N.; He, Q.; Wang, Y.; Wang, R.; Xu, F. Effects of five heavy metals at sub-lethal concentrations on the growth and photosynthesis of Chlorella vulgaris. Chin. Sci. Bull. 2012, 57, 3363–3370. [Google Scholar] [CrossRef]
- Mohamed, A.A.; Ali, S.I.; Darwesh, O.M.; El-Hallouty, S.M.; Sameeh, M.Y. Chemical compositions, potential cytotoxic and antimicrobial activities of Nitraria retusa methanolic extract sub-fractions. Int. J. Toxicol. Pharmacol. Res. 2015, 7, 204–212. [Google Scholar]
- Sayik, A.; Yusufoglu, A.S.; Leyla, A.Ç.; Turer, G.; Aydin, B.; Arslan, L. DNA binding, biological activities and chemical composition of wild growing Epilobium angustifolium L. extracts from Canakkale, Turkey. J. Turk. Chem. Soc. Sect. 2017, 4, 811–840. [Google Scholar] [CrossRef]
- Sosa, A.A.; Suhaila Husaein Bagi, S.H.; Hameed, I.H. Analysis of bioactive chemical compounds of Euphorbia lathyrus using gas chromatography-mass spectrometry and Fourier-transform infrared spectroscopy. J. Pharmacogn. Phytother. 2016, 8, 109–126. [Google Scholar]
- Zhang, Z.L.; Luo, Z.H.; Shi, H.W.; Zhang, L.X.; Ma, X.J. Research advance of functional plant pharmaceutical cycloartenol about pharmacological and physiological activity. China J. Chin. Mater. Med. 2017, 42, 433–437. [Google Scholar]
- Ramírez-Moreno, E.; Cariño-Cortés, R.; Cruz-Cansino, N.; Delgado-Olivares, L.; Ariza-Ortega, J.A.; Montañez-Izquierdo, V.Y.; Hernández-Herrero, M.M.; Filardo-Kerstupp, T. Antioxidant and antimicrobial properties of cactus pear (Opuntia) seed oils. J. Food Qual. 2017, 2017, 3075907. [Google Scholar] [CrossRef]
- Moosazadeh, E.; Akhgar, M.R.; Kariminik, A. Chemical composition and antimicrobial activity of Opuntia stricta F. essential oil. J. Biodivers. Environ. Sci. 2014, 4, 94–101. [Google Scholar]
- Burt, S. Essential oils: Their antibacterial properties and potential applications in foods—A review. Int. J. Food Microbiol. 2004, 94, 223–253. [Google Scholar] [CrossRef]
- Ortega, M.D.L.A.O.; Cruz-Cansino, N.D.S.; Alanís-García, E.; Delgado-Olivares, L.; Ariza-Ortega, J.A.; Ramírez-Moreno, E.; Manríquez-Torres, J.J. Optimization of ultrasound extraction of cactus pear (Opuntia ficus indica) seed oil based on antioxidant activity and evaluation of its antimicrobial activity. J. Food Qual. 2017, 2017, 9315360. [Google Scholar] [CrossRef]
- Zekaria, D. Los Aceites Esenciales Una Alternativa a los Antimicrobianos. Laboratorios Calier. 2007. Available online: https://www.calier.es/pdf/Microsoft_Word__Aceites_esen_como_promotores.pdf (accessed on 20 August 2022).
- Viuda-Martos, M.; Mohamady, M.A.; Fernández-López, J.; Abd ElRazik, K.A.; Omer, E.A.; Pérez-Alvarez, J.A.; Sendra, E. In vitro antioxidant and antibacterial activities of essentials oils obtained from Egyptian aromatic plants. Food Control 2011, 22, 1715–1722. [Google Scholar] [CrossRef]
- Gomez-Alvarez, C.A.; Leal-Castro, A.L.; Perez de Gonzalez, P.; Navarrete-Jiménez, M. L Mecanismos de resistenciaen Pseudomonas aeruginosa: Entendiendo a un peligroso enemigo. Rev. Fac. Med. Univ. Nac. Colomb. 2005, 53, 27–34. [Google Scholar]
- Khémiri, I.; Hédi, B.E.; Zouaoui, N.S.; Gdara, N.B.; Bitri, L. The antimicrobial and wound healing potential of Opuntia ficus- indica L. inermis extracted oil from Tunisia. Hindawi Evid. Based Complement. Altern. Med. 2019, 2019, 9148782. [Google Scholar] [CrossRef]
- Abdel Fattah, M.S.; Badr, S.E.A.; Khalil, E.M.; Elsaid, A.S. Feed efficiency, some blood parameters and In-vitro chemoprevention of prickly pear (Opuntia ficus indica L.) seeds oil growing in Egypt. IBSPR 2020, 8, 20–28. [Google Scholar]
- Camarena-Ordonez, D.R.; Gutierrez-Uribe, J.; Hernandez-Brenes, C.; Mertens-Talcott, S. Prickly pear seed extracts with antioxidant and cancer-preventing capacity. FASEB J. 2010, 24, 928.17. [Google Scholar] [CrossRef]
- Zhang, C.; Yu, H.; Shen, Y.; Ni, X.; Shen, S.; Das, U.N. Polyunsaturated fatty acids trigger apoptosis of colon cancer cells through a mitochondrial pathway. Arch. Med. Sci. 2015, 11, 1081–1094. [Google Scholar]
- Hasani, N.A.; Yussof, P.A.; Khalid, B.A.K.; Ghapor, M.T.A.; Ngah, W.Z.W. The possible mechanism of action of palm oil gammatocotrienol and alpha-tocopherol on the cervical carcinoma caski cell apoptosis. Biomed. Res. Int. 2008, 19, 194–200. [Google Scholar]
- Zingg, J.M. Modulation of signal transduction by vitamin E. Mol. Asp. Med. 2007, 28, 481–506. [Google Scholar] [CrossRef]
- Christen, S.; Woodall, A.A.; Shigenaga, M.K.; Southwell-Keely, P.T.; Duncan, M.W.; Ames, B.N. γ-tocopherol traps mutagenic electrophiles such as NOX and complements α-tocopherol: Physiological implications. Proc. Natl. Acad. Sci. USA 1997, 94, 3217–3222. [Google Scholar] [CrossRef]
- Becer, E.; Kabadayı, H.; Meriçli, F.; Meriçli, A.H.; Kıvançlı, B.; Vatansever, S. Apoptotic effects of Opuntia ficus indica L. seed oils on colon adenocarcinoma cell lines. Proceedings 2018, 2, 1566. [Google Scholar]
- Koshak, A.E.; Abdallah, H.M.; Esmat, A.; Rateb, M. Anti-inflammatory activity and chemical characterization of Opuntia ficus-indica seed oil cultivated in Saudi Arabia. Arab. J. Sci. Eng. 2020, 45, 4571–4578. [Google Scholar] [CrossRef]
- Khomdram, S.D.; Singh, P.K. Polyphenolic compounds and free radical scavenging activity in eight Lamiaceae herbs of Manipur. Not. Sci. Biol. 2011, 3, 108–113. [Google Scholar] [CrossRef][Green Version]
- Ahmad, A.; Davies, J.; Randall, S.; Skinner, G.R. Antiviral properties of extract of Opuntia streptacantha. Antivir. Res. 1996, 30, 75–85. [Google Scholar] [CrossRef]

| Fatty Acids | % |
|---|---|
| Saturated fatty acids | |
| Myristic acid C14:0 | 0.05 |
| Palmitic acid C16:0 | 6.73 |
| Margaric acid C17:0 | 0.06 |
| Stearic acid C18:0 | 5.74 |
| Arachidic acid C20:0 | 0.23 |
| Behenic acid C22:0 | 0.17 |
| Monounsaturated fatty acids | |
| Palmitoleic acid C16:1 | 0.10 |
| Oleic acid C18:1 | 21.10 |
| Eicosanoic acid (Gondoic acid) C20:1 | 0.34 |
| Erucic acid C22:1 | 0.76 |
| Polyunsaturated fatty acids | |
| Linoleic acid C18:2 | 14.00 |
| Linolenic acid C18:3 | 50.69 |
| Σ SFA | 12.98 |
| Σ MUFA | 22.30 |
| Σ PUFA | 64.69 |
| Compound | RT | Concentration μg/mL |
|---|---|---|
| A-Tocopherol | 5.0 | 4.00 |
| γ-Tocopherol | 7.0 | 9.88 |
| Β-Tocopherol | 11.0 | 10.14 |
| Total tocopherols | - | 24.02 |
| Compound Name | RT | Area % | Molecular Formula | Molecular Weight |
|---|---|---|---|---|
| Hexadecanoic acid, methyl ester (Palmitic acid, methyl ester) | 7.59 | 6.95 | C17H34O2 | 270 |
| 9,12,15-Octadecatrienoic acid, methyl ester, (Z,Z,Z)- (Linolenic acid, methyl ester) | 9.13 9.65 | 5.52 8.97 | C19H32O2 | 292 |
| 7,10,13-Eicosatrienoic acid, methyl ester (Methyl eicosa-7,10,13-trienoate) | 11.55 | 7.52 | C21H36O2 | 320 |
| 9-Octadecenoic acid, 12-hydroxy-, methyl ester, [R-(Z)]- (Methyl ricinoleate) | 11.81 | 6.88 | C19H36O3 | 312 |
| Eicosanoic acid, methyl ester (Arachidic acid—methyl ester) | 11.87 | 4.00 | C21H42O2 | 326 |
| Stigmast-5-en-3 ol,(3á,24S)- | 12.01 | 2.34 | C29H50O | 414 |
| 6,9,12-Octadecatrienoic acid, methyl ester | 12.31 | 0.88 | C19H32O2 | 292 |
| 13-Docosenoic acid, methyl ester | 12.74 | 15.10 | C23H44O2 | 352 |
| Tetracosanoic acid, methyl ester | 14.25 | 2.19 | C25H50O2 | 382 |
| Docosanoic acid, methyl ester (Behenic acid, methyl ester) | 15.53 | 0.89 | C23H46O2 | 354 |
| Hexacosanoic acid, methyl ester | 15.59 | 1.58 | C27H54O2 | 410 |
| 6,8-di-c-á-glucosylluteolin | 16.45 | 1.37 | C27H30O16 | 610 |
| á-Sitosterol | 16.76 | 1.67 | C29H50O | 414 |
| 1H-Purin-6-amine, (2fluorophenyl)methyl)- | 17.49 | 4.75 | C12H10FN5 | 243 |
| Campesterol | 18.04 | 4.15 | C28H48O | 400 |
| Stigmasterol | 18.30 | 1.36 | C29H48O | 412 |
| ç-Sitosterol | 19.07 | 2.05 | C29H50O | 414 |
| 9,19-Cyclolanost-24-en-3-ol, (3á)-(Cycloartenol) | 19.98 | 3.24 | C30H50O | 426 |
| 3′,4′,7Trimethylquercetin | 22.80 | 1.77 | C18H16O7 | 344 |
| Microbial Species | Zone of Inhibition (mm, Mean ± SEM) | MIC (µg/mL) | MBC (µg/mL) | * Oxytetracycline 30 mg | * Penicillin 10 mg |
|---|---|---|---|---|---|
| S. aureus | 17.3± 0.4 | 20 | 25 | ND | _____ |
| B. subtilis | 14.4 ± 0.5 | 25 | 35 | 5.1 ± 0.5 | _____ |
| E. coli | 21.2 ± 0.2 | 15 | 20 | 17.0 ± 0.3 | _____ |
| K.pneumoniae | 18.3 ± 0.4 | 20 | 25 | ND | _____ |
| S. cerevisiae | 28.3 ± 0.4 | 10 | 15 | 9.2 ± 0.6 | _____ |
| Asp.niger | ND | ND | ND | ND | ND |
| Pen.digitatum | 9.4 ± 0.5 | 35 | 40 | _____ | 4.4 ± 0.5 |
Publisher’s Note: MDPI stays neutral with regard to jurisdictional claims in published maps and institutional affiliations. |
© 2022 by the authors. Licensee MDPI, Basel, Switzerland. This article is an open access article distributed under the terms and conditions of the Creative Commons Attribution (CC BY) license (https://creativecommons.org/licenses/by/4.0/).
Share and Cite
Alqurashi, A.S.; Al Masoudi, L.M.; Hamdi, H.; Abu Zaid, A. Chemical Composition and Antioxidant, Antiviral, Antifungal, Antibacterial and Anticancer Potentials of Opuntia ficus-indica Seed Oil. Molecules 2022, 27, 5453. https://doi.org/10.3390/molecules27175453
Alqurashi AS, Al Masoudi LM, Hamdi H, Abu Zaid A. Chemical Composition and Antioxidant, Antiviral, Antifungal, Antibacterial and Anticancer Potentials of Opuntia ficus-indica Seed Oil. Molecules. 2022; 27(17):5453. https://doi.org/10.3390/molecules27175453
Chicago/Turabian StyleAlqurashi, Abeer S., Luluah M. Al Masoudi, Hamida Hamdi, and Abeer Abu Zaid. 2022. "Chemical Composition and Antioxidant, Antiviral, Antifungal, Antibacterial and Anticancer Potentials of Opuntia ficus-indica Seed Oil" Molecules 27, no. 17: 5453. https://doi.org/10.3390/molecules27175453
APA StyleAlqurashi, A. S., Al Masoudi, L. M., Hamdi, H., & Abu Zaid, A. (2022). Chemical Composition and Antioxidant, Antiviral, Antifungal, Antibacterial and Anticancer Potentials of Opuntia ficus-indica Seed Oil. Molecules, 27(17), 5453. https://doi.org/10.3390/molecules27175453

